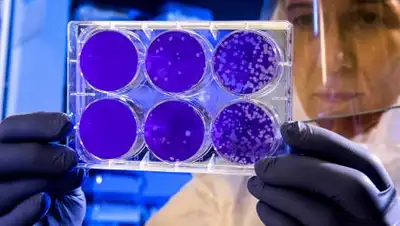
pxhere.com, фото - Новости Zakon.kz от 05.08.2021 19:11

В Китае создали лампу, убивающую коронавирус на 99,99%
pxhere.com
pxhere.com
Новая лампа также может уничтожать и другие опасные бактерии, в том числе золотистый стафилококк.
О создании ультрафиолетовой дезинфицирующей лампы, способной обеззараживать помещения от коронавируса, заявили китайские ученые. По словам разработчиков, она в силах уничтожить 99,99% вирусов, сообщает zakon.kz.
Устройство успешно испытали в центре по контролю и предотвращению инфекционных заболеваний китайской провинции Хубэй и рекомендовали его для процедур по дезинфекции, передает China Daily.
По данным издания, устройство потребляет сравнительно мало энергии и сможет проработать до 50 тыс. часов. Новая лампа также может уничтожать и другие опасные бактерии, в том числе золотистый стафилококк.
Ранее японские ученые доказали, что ультрафиолетовое излучение убивает коронавирусы.
Поделитесь новостью
Читайте также
Если вы видите данное сообщение, значит возникли проблемы с работой системы комментариев. Возможно у вас отключен JavaScript

















